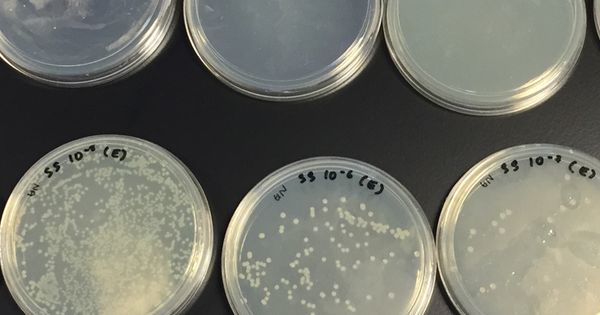

Chem Lab Supplies petri dishes,that can withstand repeated auto-claving. Bottom part and cover lid are both very flat. This evenness facilitates the uniform spreading of nutrient media and liquids. #agarpetridish #buylabglasswareonlineSouthAfrica #chemi chemlabsupplies.co.za/product/petri-…
Search
DIY! Try this out :) It'll be fun 😊
Video : @Melscience
.
.
.
#sciencehook #chemistry #chemi #chemistryexperiments #sciencegeek #chemistry_lab #chemistryclass #chemistrylab #chemistryteacher #chemistrylife #chemistryboys #scienceisawesome #sciencenerd #science #sciencelabO
2
4
We LOVE density! Chem I finished up their density lab today! D=❤️ #ndchemistry #chemI instagram.com/p/BnXdHYpBHkE/…
Just Pinned to Science Lab Photos (ift.tt/2lDaauD): The result of the serial dilutions and plating of bacterial cultures. #chemi…
Just Pinned to Science Lab Photos (ift.tt/2g0rkA7): The result of the serial dilutions and plating of bacterial cultures. #chemi…
Just Pinned to Science Lab Photos (ift.tt/2x0Tlfj): The result of the serial dilutions and plating of bacterial cultures. #chemi…
Just Pinned to Science Lab Photos (ift.tt/2vdNfpl): The result of the serial dilutions and plating of bacterial cultures. #chemi…
Just Pinned to Science Lab Photos (ift.tt/2eOswpx): The result of the serial dilutions and plating of bacterial cultures. #chemi…
Just Pinned to Science Lab Photos (ift.tt/2tAXFSL): The result of the serial dilutions and plating of bacterial cultures. #chemi…